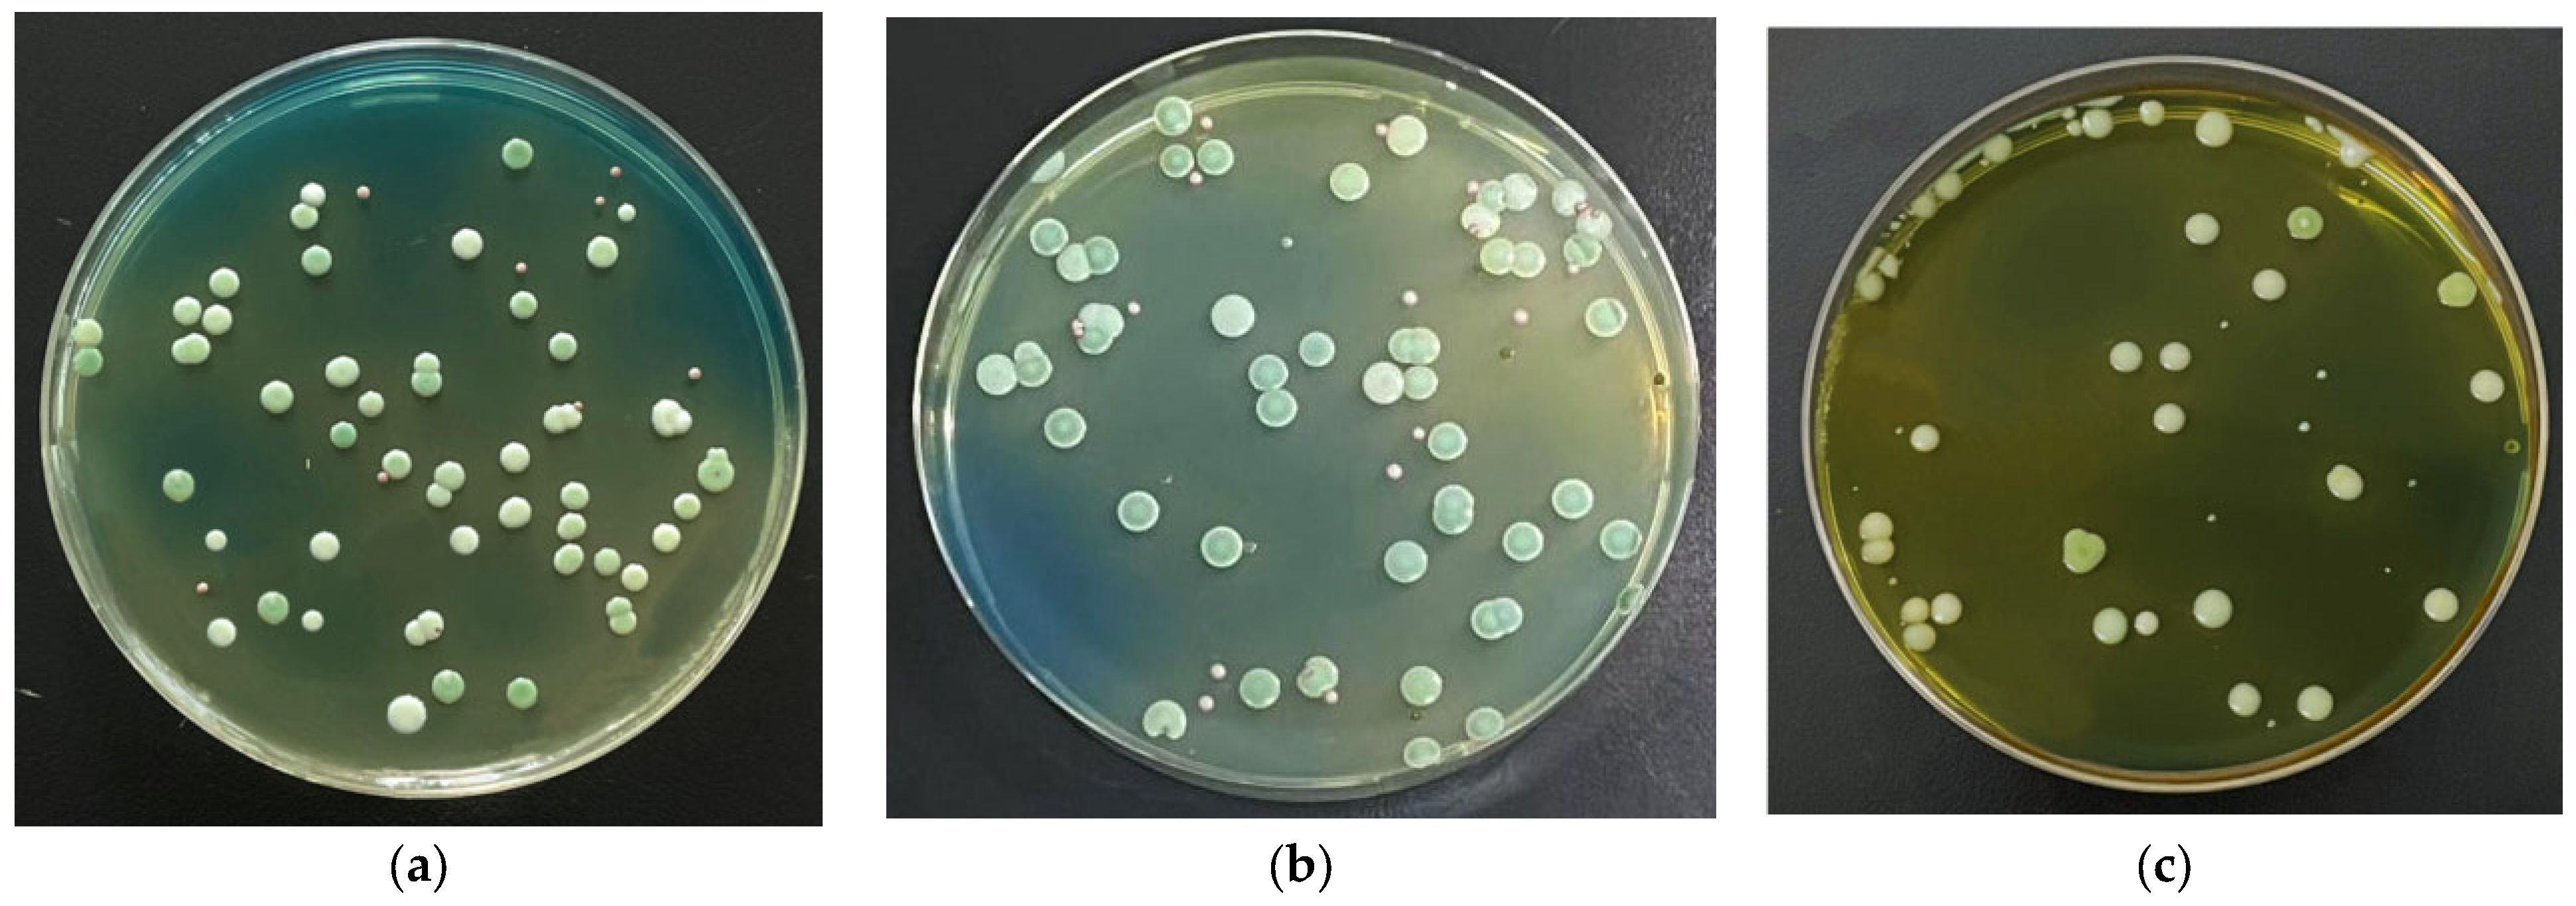
Foods 14 03471 g005
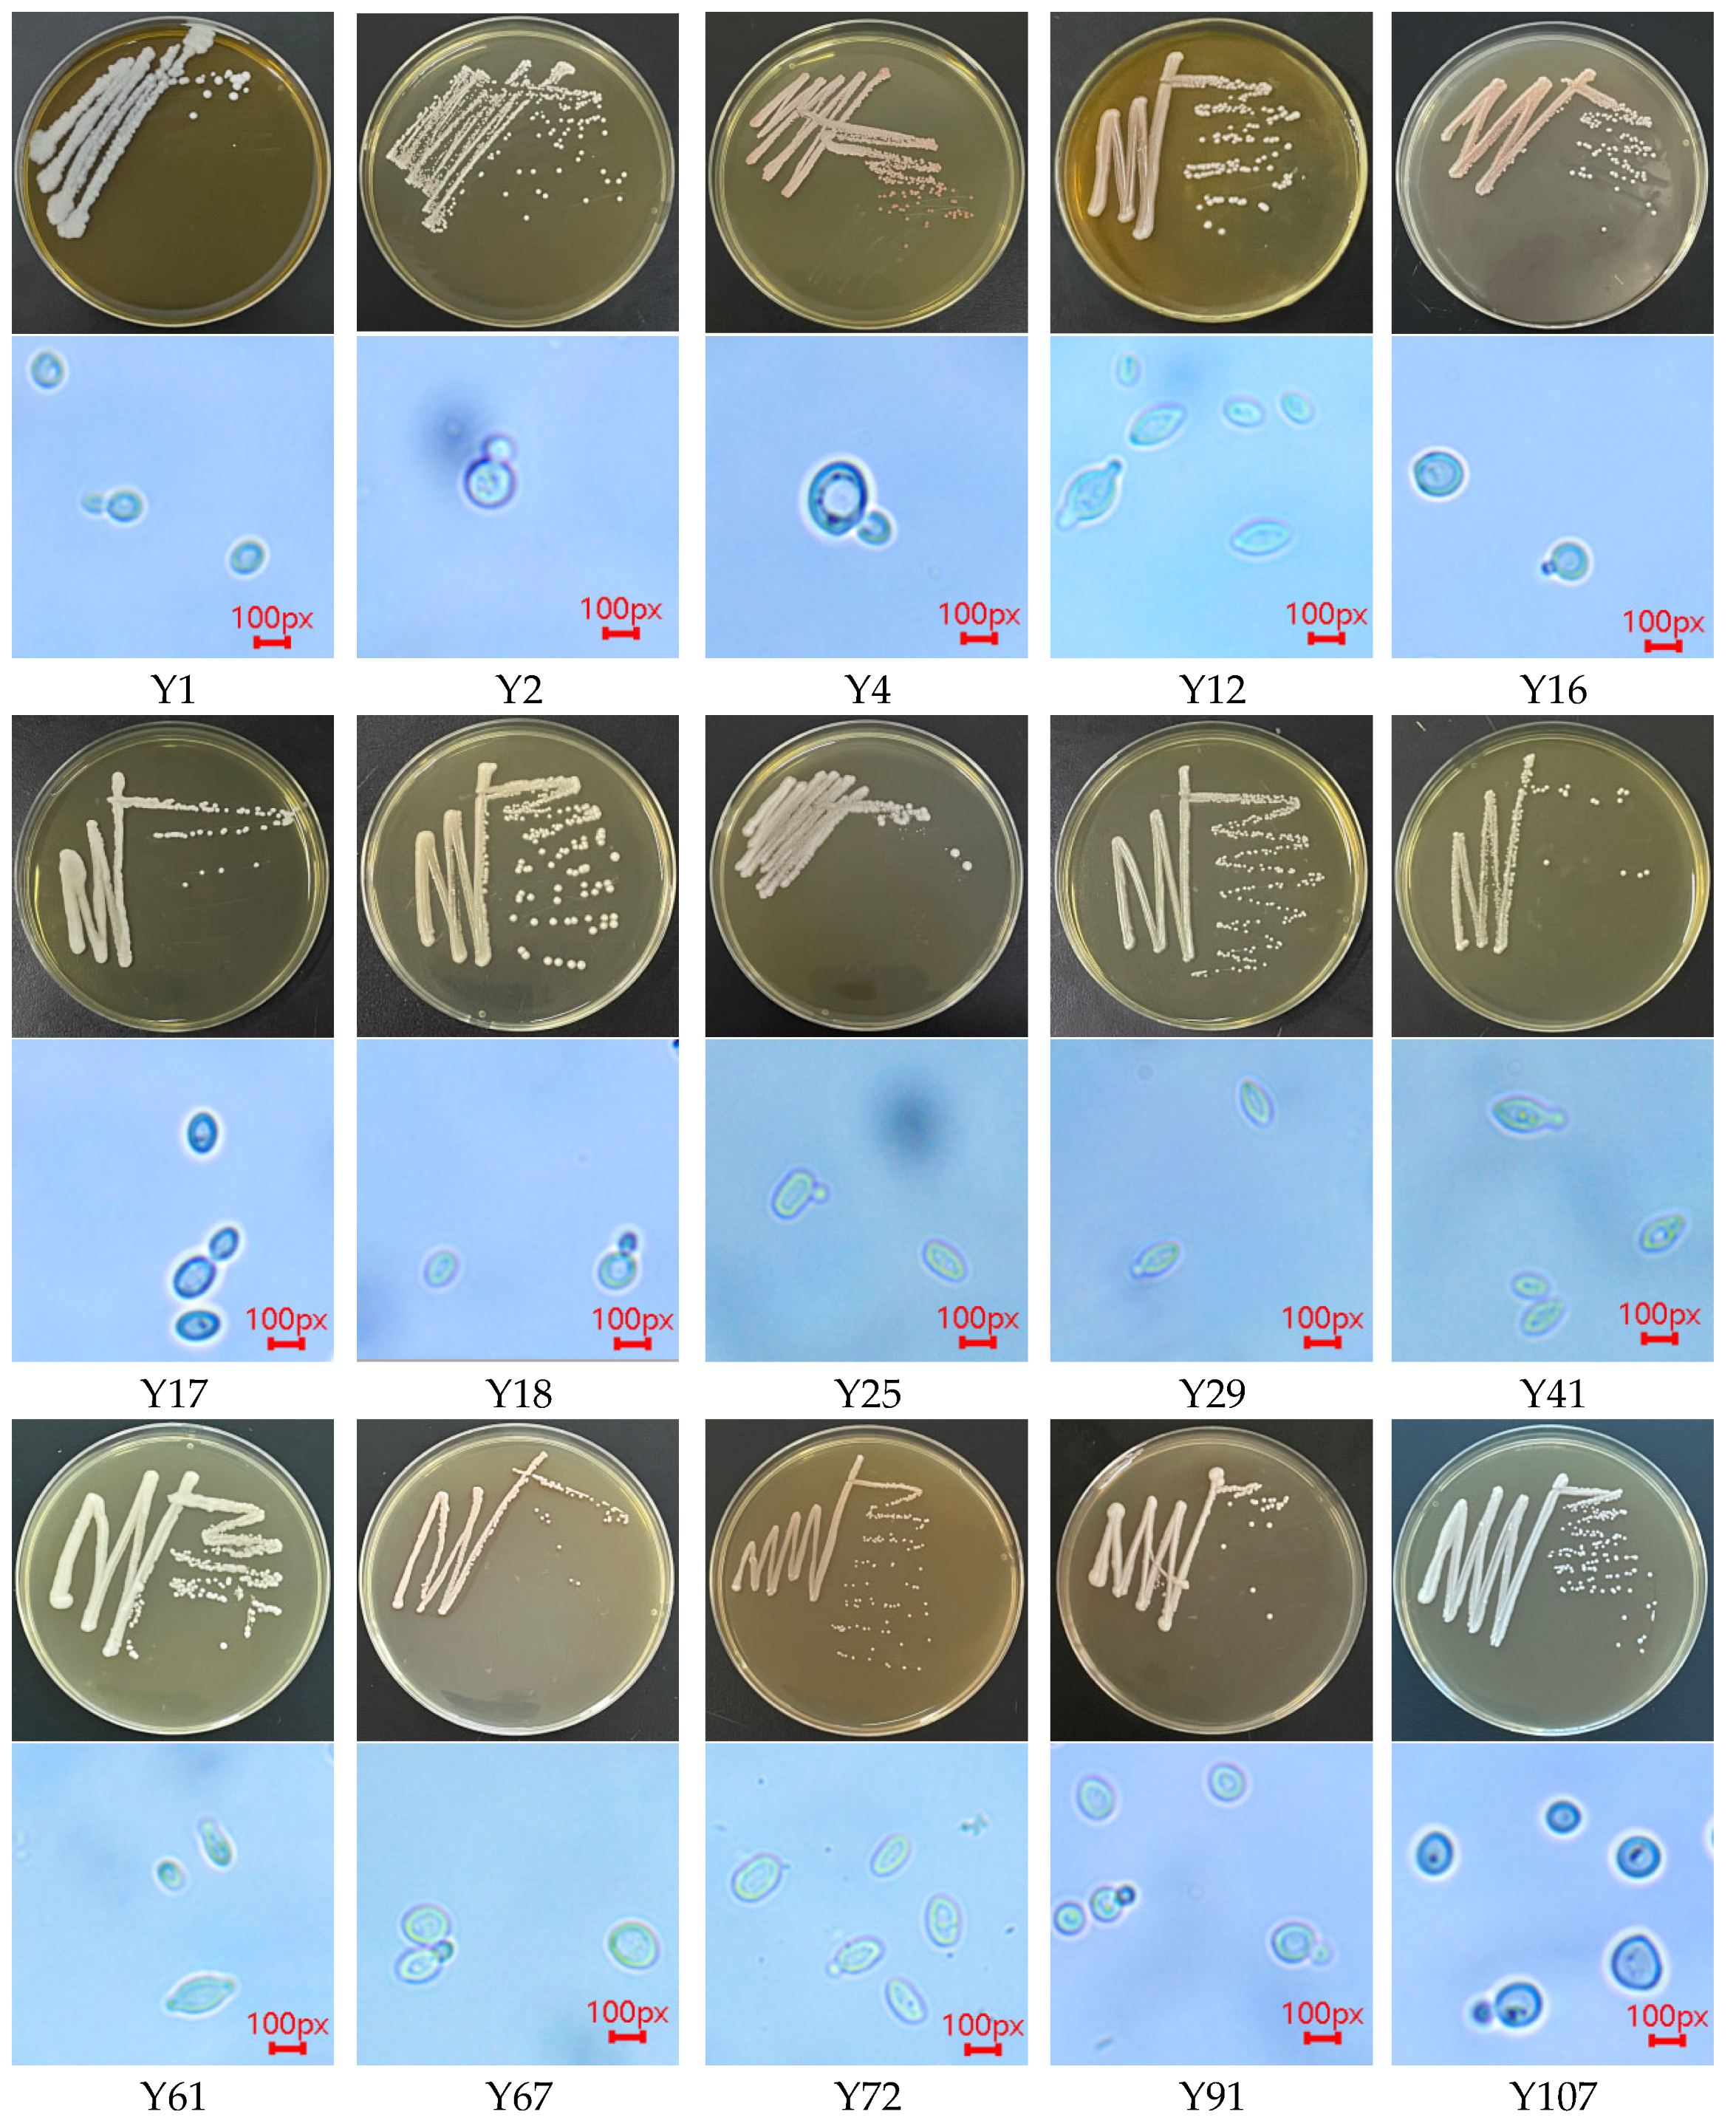
Foods 14 03471 g006

1. Introduction
Msalais is a specialty of Xinjiang. It is a delicious and mellow wine drink produced through boiling and natural fermentation. It has high medicinal value and is rich in amino acids, vitamins, glucose, iron, and other nutrients and trace elements needed by the human body. In recent years, as people’s attention to healthy eating continues to increase, Msalais has been favored for its unique taste and potential health benefits. Its unique flavor and color are derived from complex biochemical conversion processes [
1]. In the traditional process, grape juice is boiled and fermented for a long time to form a dark brown and rich aroma. This process involves the deep participation of the Maillard reaction. As an early stable intermediate product of the Maillard reaction, the Amadori compound is not only the precursor of subsequent flavor substances but also has physiological activities [
2] such as antioxidant activity, which may have a key impact on the storage stability and health attributes of Msalais. The Amadori compound is a carbonyl amine condensation reaction between reducing sugar substances such as glucose and fructose in fruit and vegetable raw materials as carbonyl donors and free amino groups contained in amino acids, peptides, and proteins. After Amadori rearrangement, the formation of 1-amino-1-deoxy-2-keto sugar, that is, the Amadori compound. The specific process is shown in
Figure 1. Amadori compounds are generally solid, yellow, or white, easily soluble in water, methanol, and ethanol, and have no odor but are important non-volatile aroma precursors [
3]. At present, there are studies on the end-stage products of the Maillard reaction in Msalais, such as acrylamide and 5-hydroxymethylfurfural [
4], but the study of Amadori compounds in Msalais has not been reported. In Hotan red grape juice, before boiling, the content of proline was 284.68 mg/mL, and the content of aspartic acid was 8.86 mg/mL [
5], which could provide sufficient amino acid substrates for the formation of Amadori compounds, and the two Amadori compounds were proved to have more functions, such as antibacterial, anticancer, antioxidant, etc. [
6,
7,
8]. In order to improve the function of Msalais, Fru-Pro and Fru-Asp were selected as two Amadori compounds for subsequent research.
Amadori compounds, whose substrates, reducing sugars and amino acids, are the basic nutrients of food, have high reactivity. Therefore, Amadori compounds are widely found in tomato powder, chili powder, black garlic, and dried fruits and vegetables [
9]. Amadori compounds have long been considered to have a negative impact on food quality and nutrition and human health [
10]. For example, the loss of active ingredients such as amino acids and sugars in foods can lead to lower bioavailability of Amadori compounds. After being partially absorbed, they are excreted out of the body and cannot be used by organisms, which reduces the nutritional value of food [
11]. The safety issues associated with Amadori compounds cannot be ignored. Overheating of Amadori compounds can produce advanced glycation end products and acrylamide [
12], which may pose a health risk to diabetic patients. Therefore, the heating time needs to be strictly controlled during the enrichment of Amadori compounds. However, with the deepening of research, some Amadori compounds have been proven to have beneficial physiological effects on the human body. Yu [
13] showed that Amadori compounds can inhibit cardiovascular and cerebrovascular diseases because they can effectively inhibit the activity of angiotensin-converting enzyme; Ha et al. [
14] found that Amadori compounds with arginine residues can inhibit the activity of pancreatic amylase and glucosidase, thereby reducing the digestion and absorption of carbohydrates in the gastrointestinal tract, reducing the increase in postprandial blood glucose, thus playing a role in lowering blood glucose. Mossine [
15] found that Fru-His can synergistically inhibit the proliferation of prostate cancer cells in vitro and in vivo, and an experimental diet supplemented with tomato paste and Fru-His can reduce the carcinogenic effect of carcinogenic rat prostate by 6 times. Therefore, more and more studies have focused on how to improve Amadori compounds by optimizing food processing technology.
At present, there have been reports on various detection methods of Amadori compounds. A classic amino acid analysis method, the post-column ninhydrin derivatization assay, has been used for the analysis of Amadori compounds [
16]. However, this method has many shortcomings, such as insufficient separation, poor sensitivity, and a time-consuming process. The method of using trimethylsilane to partially derivatize sugars in the gas phase [
17] has also been used for the analysis of Amadori compounds, but this method requires a long time of derivatization, and the separation process is extremely complicated due to the formation of tautomers. Yu et al. [
18] used ligand exchange and scanning capillary electrophoresis to directly detect Amadori compounds by ultraviolet detection (UV). At present, the most commonly used methods for the analysis and determination of Amadori compounds are high-performance liquid chromatography, ion chromatography, etc. High-performance liquid chromatography mainly uses different types of chromatographic columns to separate Amadori compounds from other substances and then detect them with an ultraviolet detector, fluorescence detector, or evaporative light scattering detector. Most Amadori compounds have low ultraviolet absorption or no fluorescence characteristics, so it is usually necessary to introduce derivatization steps to improve the detection sensitivity [
18], while evaporative light detectors respond to all substances and can detect Amadori compounds without complex pre-treatment. Li [
19] synthesized and purified four Amadori compounds under aqueous conditions and used high-performance liquid chromatography–evaporative light detector to detect their purity up to 98%. High performance anion chromatography tandem pulsed amperometric detector [
20] (HPAEC-PAD) and high performance anion chromatography tandem mass spectrometry (HPAEC-MS) have also been widely used in the qualitative analysis of Amadori compounds. In addition, high-performance liquid chromatography–tandem mass spectrometry has also been widely used.
Based on the above background, this study aims to develop a Msalais rich in Amadori compounds by using the fermentation performance of different yeasts. The Amadori compounds in Msalais were detected by high-performance liquid chromatography–evaporative light detector, and different yeasts were screened, and their fermentation performance was evaluated. Through a single-factor experiment and response surface optimization, the strain and optimum fermentation conditions of mixed fermentation were determined. The antioxidant capacity of the developed Msalais was studied, and the effect of the increase in Amadori compound content on the antioxidant capacity of Msalais was evaluated. These results may provide a new way for studying microorganisms in the Maillard reaction and open up the possibility for the wide application of Amadori compounds in the food industry and other industries.
2. Materials and Methods
2.1. Chemicals
Hetian were red grapes sourced from Awati County (Aawti, China); Fru-Asp (1-deoxy-1-L-aspartate-D-fructose) and Fru-Pro (1-deoxy-1-L-proline-D-fructose) at a purity > 95% was obtained from TRC Company (Toronto, ON, Canada); Chromatographic pure acetonitrile was purchased from Beijing Zeping Technology Co., Ltd. (Beijing, China); 2,3,5-triphenyltetrazolium chloride was obtained from Sinopharm Chemical Reagent Co., Ltd. (Shanghai, China); Dowex 50WX4 Hydrogen Ion Exchange Resin (200~400 mesh) was obtained from J&K Scientific (Beijing, China); ammonium formate (chromatographically pure) was obtained from Weiqi Boxing Biotechnology Co., Ltd. (Wuhan, China); Yeast genomic DNA rapid extraction kit was purchased from Beijing Solebold Technology Co., Ltd. (Beijing, China); WL nutrient agar was obtained from CoolLebo Technology Co., Ltd. (Beijing, China); phosphate buffer solution was obtained from Kaiji Biotechnology Co., Ltd. (Nanjing, China); DPPH (1,1-diphenyl-2-picrylhydrazyl), ABTS (2,2′-azino-bis-3-ethylbenzothiazoline-6-sulfonic acid), and Trolox (6-hydroxy-2,5,7,8-tetramethylchroman-2-carboxylic acid) were obtained from Yuanye Technology Co., Ltd. (Shanghai, China); fluorescein sodium and AAPH (2,2-azobis (2-methylpropylimidazole) dihydrochloride) were obtained from Aladdin Biotechnology Co., Ltd. (Shanghai, China); Angel Aroma Active Dry Yeast Powder (AQSX) was obtained from Angel Yeast Co., Ltd. (Yichang, China); other reagents in the test were of analytical purity.
2.2. Instruments
High Performance Liquid Chromatograph-Evaporative Light Scattering Detector purchased from Shimadzu, Japan (Kyoto, Japan); XBridge BEH Amide (5 μm, 4.6 mm × 250 mm) column purchased from Waters (Milford, MA, USA); Open-glass sand-core chromatography column (20 mm × 60 cm) was obtained from Rhoda Henghui Company (Beijing, China); Rotary evaporator from Shanghai Haozhuang Instrument Co., Ltd. (Shanghai, China); LDZX-50L Vertical High Pressure Steam Sterilizer Purchased from Shenan Medical Device Factory (Shanghai, China); GZX-9140MBE electric blower dryer was purchased from Boxun Instrument Co., Ltd. (Shanghai, China); Biomicroscope purchased from Jiangnan Yongxin Optical Co., Ltd. (Nanjing, China); Thermostatic incubator was purchased from Yiheng Technology Co., Ltd. (Shanghai, China); Biomicroplate reader obtained from Thermo Fisher Scientific (Waltham, MA, USA).
2.3. Preparation of Grape Juice Rich in Amadori Compounds
Hotan red grapes with more than 80% maturity, with full particles, and with no mechanical damage were selected and washed. After removing the stem and crushing, the grape juice was boiled and concentrated to a sugar content of 21 °BX after pressing and extracting the juice. The grape skin and water were boiled and concentrated to a sugar content of 21 °BX at a ratio of 2:1 (kg:L), and the oil bath was heated using a laminated pan. The specific process is shown in
Figure 2. The filtered grape skin juice and grape juice were mixed and poured into a laminated pan to be boiled; the heating concentration temperature was set at 140 °C, and the final sugar content was 27 °BX. After cooling to room temperature (20–23 °C), it was frozen at −18 °C.
2.4. Establishment of HPLC-ELSD Method for the Detection of Amadori Compounds
2.4.1. Chromatographic Conditions
According to the method of Li [
19], some modifications were made: The chromatographic column was an XBridge BEH Amide (5 μm, 4.6 mm × 250 mm). The mobile phase was acetonitrile–ammonium formate = 80:20; the flow rate was 1.0 mL/min; and the column temperature was 35 °C. The injection volume was 10 μL; the evaporative light scattering detector drift tube temperature was 40 °C, the gain was 6, nitrogen was used as a carrier gas. The mobile phase was acetonitrile (phase A) and a 10 mmol/L ammonium formate aqueous solution (phase B), respectively. The gradient elution method was used for the determination. The gradient change in mobile phase A was as follows: from 0 min to 5 min, the volume fraction of phase A changed from 80% to 70%; from 5 min to 10 min, the volume fraction of phase A changed from 70% to 65%; from 10 min to 11 min, the volume fraction of phase A changed from 65% to 80%; from 11 min to 15 min, the volume fraction of phase A changed from 65% to 80%; the total time was 20 min.
2.4.2. Sample Pretreatment
The 500 mL sample solution was diluted with an equal volume of ultrapure water, added with an appropriate amount of activated carbon powder to adsorb impurities such as pigments, and this was centrifuged at 6000 rpm for 10 min. The supernatant was filtered by medium-speed qualitative filter paper and allowed to stand for later use. The pretreated Dowex 50WX4 (Thermo Fisher Scientific) hydrogen ion exchange resin (200~400 mesh) was loaded into the chromatographic column, and the excess water was discharged by settling with ultrapure water to half of the column height. A 1 L diluted sample solution was injected into the chromatographic column, and after it flowed out naturally, it was washed with a large amount of ultrapure water to remove impurities such as glucose. Elution was performed with 0.2 mol/L ammonia water, and the TTC test positive eluent (each 10 mL as a group) was collected in sections until the TTC test was negative [
21]. Then, the resin was washed with ultrapure water to neutral, soaked in 0.1 mol/L dilute hydrochloric acid for 30 min, washed with ultrapure water again to remove the acid solution, and the resin was recovered for backup. The collected eluent was vacuum-distilled at 55 °C for 30 min and concentrated for analysis.
2.4.3. Methodological Investigation
The 10 mg Fru-Asp and Fru-Pro standards were accurately weighed, dissolved in ultrapure water, and diluted to 10 mL in volumetric flasks to prepare a 1000 μg/mL standard stock solution, which was stored in the dark at 4 °C. In the actual detection, the Fru-Pro standard was dissolved in ultrapure water and diluted to 500, 400, 300, 200, and 100 μg/mL, and the Fru-Asp was dissolved in ultrapure water and diluted to 5, 10, 100, 200, and 300 μg/mL. The HPLC-ELSD detection was performed according to the chromatographic conditions of
Section 2.4.1, and the chromatogram was recorded.
- 2.
Linear relationship investigation
The Fru-Pro standard was dissolved in ultrapure water and diluted to 500, 400, 300, 200, and 100 μg/mL, and the Fru-Asp was dissolved in ultrapure water and diluted to 5, 10, 100, 200, and 300 μg/mL. HPLC-ELSD detection was performed according to the chromatographic conditions of
Section 2.4.1. The standard curve was drawn with the peak area as the
y-axis and the standard concentration of Fru-Pro and Fru-Asp as the
x-axis, and the correlation coefficient R
2 was calculated.
- 3.
Accuracy test
The Fru-Pro standard was dissolved in ultrapure water and diluted to 250 μg/mL, and a total of 3 Fru-Pro aqueous solutions were prepared. The Fru-Asp was dissolved in ultrapure water and diluted to 10 μg/mL. A total of 3 parts of Fru-Asp aqueous solution were prepared. Six standard solutions were detected by HPLC-ELSD according to the chromatographic conditions of
Section 2.4.1. The peak area was recorded, and the relative standard deviation RSD was calculated.
- 4.
Precision test
The Fru-Pro standard was dissolved in ultrapure water and diluted to 250 μg/mL. Fru-Asp was dissolved in ultrapure water and diluted to 10 μg/mL. HPLC-ELSD detection was performed according to the chromatographic conditions of
Section 2.4.1. Each standard solution was injected repeatedly 6 times, the peak area was recorded, and the relative standard deviation RSD was calculated.
- 5.
Repeatability test
Msalaisi from Miandu Distillery was used as the sample solution. The sample solution was pretreated according to
Section 2.4.2 to obtain the sample solution to be tested. A total of 1 mL of the sample solution to be tested was taken and detected by HPLC-ELSD according to the chromatographic conditions of
Section 2.4.1. The sample was injected repeatedly 6 times, the peak area was recorded, and the content of Amdori compounds and the relative standard deviation RSD were calculated according to the standard curve.
- 6.
Stability test
The sample solution was taken and pretreated according to the method of
Section 2.4.2 to obtain the sample solution to be tested. The sample solution to be tested was held at 20 °C for 0, 6, 12, 18, 24, 30, and 36 h, respectively. HPLC-ELSD detection was performed according to the chromatographic conditions of
Section 2.4.1. The peak area at 0 h was used as a comparison to calculate the content changes and RSD values of Amadori compounds at different time points.
- 7.
Determination of sample content
The sample solution was taken, and the sample solution was pretreated according to the method of
Section 2.4.2 to obtain the sample solution to be tested. The 1 mL sample solution to be tested was accurately sucked and repeated three times to obtain three sample solutions to be tested. HPLC-ELSD detection was performed according to the chromatographic conditions of
Section 2.4.1, and the concentrations of the two Amadori compounds were calculated according to the standard curve.
- 8.
Standard addition recovery test
The sample solution was pretreated according to the method of
Section 2.4.2 to obtain the sample solution to be tested. The sample solution to be tested was divided into two groups, one group was added with 0.5 mL 250 μg/mL Fru-Pro standard solution, and the other group was added with 0.5 mL 10 μg/mL Fru-Asp standard solution, with 6 parts in each group. HPLC-ELSD detection was carried out according to the chromatographic conditions of
Section 2.4.1, and the average recovery rate and RSD value were calculated.
2.5. Screening of Yeast
2.5.1. Isolation and Purification of Yeast
Preparation of YPD medium was as follows: glucose 2%, peptone 2%, yeast dip 1%, chloramphenicol 0.001%, and solid medium with 2% agar powder; the above material ratios are volume ratios [
22].
Accurate weighing of soil and grapevine samples was conducted, followed by their placement into conical flasks containing 100 milliliters of sterile water. The samples were then subjected to rigorous shaking to ensure homogeneity. The 10
−1 to 10
−7 gradient dilutions were prepared sequentially, and 100 microliters of each sample was inoculated into WL medium by the dilution spread plate method. An inverted incubation at 28 °C was performed for a period of 48 h. Following this incubation, characteristic single colonies were selected and inoculated into fresh YPD medium using the streak plate method. This process was repeated until pure culture strains exhibiting consistent morphology were obtained. The appropriate amount of 30% glycerol aqueous solution was prepared and placed in a high-pressure steam sterilization pot for sterilization. After sterilization, it was taken out and cooled to room temperature (20–23 °C) and transferred to a 2 mL cryopreservation tube. The isolated strain was placed in a cryopreservation tube, shaken well, and the cryopreservation tube was stored in a refrigerator at −80 °C. The morphology of the colonies (e.g., colony size, color, surface features, etc.) was observed by a light microscope, and their characteristics were recorded [
22].
2.5.2. Molecular Biological Identification of Yeast
The isolated and purified suspected yeast strains were inoculated into YPD liquid medium and activated at 28 °C for 48 h. The bacteria were collected by centrifugation, and the genomic DNA was extracted by a yeast genomic DNA rapid extraction kit. PCR amplification was performed using ITS1 (5′-TCCGTAGGTGAACCTGCGG-3′ NR_171887.1) and ITS4 (5′-TCCTCCGCTTATTGATATATGC-3′ NR_168827.1) as primers. The reaction system (25 μL) was as follows: ddH
2O 10.5 μL, Taq mix 12.5 μL, forward/reverse primers 0.5 μL, and template DNA 1 μL. PCR conditions were as follows: 94 °C for 5 min; 94 °C denaturation 30 s, 58 °C annealing 30 s, 72 °C extension 35 s, 30 cycles; and a final extension at 72 °C for 10 min [
23]. The amplified products were detected by gel electrophoresis and sent to Xi’an Qingke Biotechnology Co., Ltd., (Xi’an, China) for sequencing. The sequencing results were compared with NCBI database, and the phylogenetic tree was constructed by the MEGA11 neighbor-joining method.
2.5.3. Rescreening of Yeast
The preserved yeast strains were inoculated in YPD liquid medium and cultured at 28 °C and 150 rpm for 48 h. The cultured yeast was transferred to a sterile centrifuge tube and centrifuged at 8000 rpm for 5 min. The precipitate was taken and dissolved in sterile water. The OD600 was measured by a microplate reader until the OD600 was 0.6–0.8. At this time, the yeast concentration was about 6–8 × 107 cells/mL. The prepared yeast seed solution was stored at 4 °C for later use.
- 2.
Determination of gas production performance
The yeast seed solution was inoculated into a Duchenne fermentation tube (containing YPD liquid medium) at 2% (
V/
V) and cultured at 28 °C for 48 h. The gas production in the fermentation tube (such as the number of bubbles, volume change) and the odor characteristics of the fermentation broth were observed and recorded regularly to evaluate the gas production capacity of the strain [
22].
- 3.
Determination of alcohol tolerance
The yeast seed solution was inoculated into YPD medium containing different concentrations of anhydrous ethanol (final concentrations were 6%, 9%, 12%, 15%, and 18%
V/
V) at a 2% (
V/
V) inoculation amount, and YPD medium without ethanol was used as a blank control. After 48 h of culture at 28 °C, the OD value at a 600 nm wavelength was measured by microplate reader to evaluate the growth of the strain at different alcohol concentrations [
22].
- 4.
Determination of acid resistance
The yeast seed solution was inoculated into YPD medium with a pH of 2.0, 2.5, 3.0, 3.5, and 4.0 (adjusted with citric acid) at a 2% (
V/
V) inoculation amount, and YPD medium without pH adjustment was used as a blank control. After incubation at 28 °C for 48 h, the OD value at a 600 nm wavelength was measured to analyze the growth adaptability of the strain under different acidic conditions [
22].
- 5.
Determination of sugar resistance
The yeast seed solution was inoculated into YPD medium with glucose concentrations of 300, 350, 400, 450, and 500 g/L at a 2% (
V/
V) inoculation amount, and YPD medium without additional glucose was used as a blank control. After incubation at 28 °C for 48 h, the OD value at a 600 nm wavelength was measured to investigate the growth characteristics of the strain in a high-glucose environment [
22].
2.6. Msalais Fermentation Single-Factor Test and Response Surface Optimization Test
2.6.1. Effect of Yeast Addition on the Content of Amadori Compounds in Msalais
Five fermentation tanks were taken, and 1 L of grape juice rich in Amadori compounds (see
Section 2.4 for preparation method) was taken in the fermentation tank. In each fermentation tank, 1%, 2%, 3%, 4%, 5% yeast seed liquid (
V/
V) was added in turn. The ratio of
Saccharomyces cerevisiae to non-
Saccharomyces cerevisiae was 2:1 (the total volume of
Saccharomyces cerevisiae and non-
Saccharomyces cerevisiae was the volume of yeast seed solution), and the fermentation was carried out at 28 °C for 14 days (336 h). The above steps were repeated three times. After the fermentation, the content of Amadori compounds in each fermentation tank was detected. Determine the optimal yeast addition amount.
2.6.2. Effect of Fermentation Temperature on the Content of Amadori Compounds in Msalais
Five fermentation tanks were taken, and 1 L of grape juice rich in Amadori compounds (see
Section 2.4 for preparation method) was taken into the fermentation tank, and a 2% yeast seed solution (
V/
V) was added to each fermentation tank. The ratio of
Saccharomyces cerevisiae to non-
Saccharomyces cerevisiae was 2:1 (the total volume of
Saccharomyces cerevisiae and non-
Saccharomyces cerevisiae was the volume of the seed liquid). The five fermentation tanks were placed in an incubator at fermentation temperatures of 22 °C, 25 °C, 28 °C, 31 °C, and 34 °C, respectively, and fermented for 14 days (336 h), repeating the above steps three times. After the fermentation, the content of Amadori compounds in the Msalais was detected in each fermentor to determine the optimal fermentation temperature [
24].
2.6.3. Effect of Fermentation Time on the Content of Amadori Compounds in Msalais
Five fermentation tanks were taken, and 1 L of grape juice rich in Amadori compounds (see
Section 2.4 for preparation method) was taken into the fermentation tank, and a 2% yeast seed solution (
V/
V) was added to each fermentation tank. The ratio of
Saccharomyces cerevisiae to non-
Saccharomyces cerevisiae was 2:1 (the total volume of
Saccharomyces cerevisiae and non-
Saccharomyces cerevisiae was the volume of the seed liquid), and the five fermentation tanks were placed at a fermentation temperature of 28 °C for 7 days (168 h), 14 days (336 h), 21 days (504 h), 25 days (600 h), and 30 days (720 h) of fermentation, and the above steps were repeated three times. After the fermentation, the content of Amadori compounds in the Msalais was detected in each fermentor to determine the optimal fermentation time.
2.6.4. The Effect of the Ratio of Saccharomyces Cerevisiae to Non-Saccharomyces Cerevisiae on the Content of Amadori Compounds in Msalais
Five fermenters were selected, and 1 L of grape juice rich in Amadori compounds (preparation method is shown in
Section 2.4) was taken into the fermenter. In each fermenter, a 2% yeast seed solution (
V/
V) was added according to the following ratios of
Saccharomyces cerevisiae to non-
Saccharomyces cerevisiae: 1:1, 1:2, 2:1, 1:3, and 3:1 (the total volume of
Saccharomyces cerevisiae and non-
Saccharomyces cerevisiae was the volume of the yeast seed solution). The fermentation temperature was 28 °C, and the fermentation was carried out for 14 days (336 h). The above steps were repeated three times. After the fermentation, the content of Amadori compounds in the Msalais was detected in each fermenter. The optimal ratio of
Saccharomyces cerevisiae to non-
Saccharomyces cerevisiae was determined.
2.6.5. Msalais Fermentation Response Surface Test
According to the optimal condition range determined by the single-factor test, the content of Fru-Pro and Fru-Asp were used as evaluation indexes. The Box–Behnken experimental design method was used to select the amount of yeast, fermentation temperature, fermentation time, and the ratio of
Saccharomyces cerevisiae to non-
Saccharomyces cerevisiae. The four-factor three-level response surface design is shown in
Table 1, and the optimal fermentation conditions were obtained according to the response surface optimization test.
2.7. Antioxidant Experiment
2.7.1. Determination of DPPH Free Radical Scavenging Ability
A 25 μL sample was mixed with 200 μL of freshly prepared 0.35 mmol/L DPPH/methanol solution and placed in the dark at room temperature (20–23 °C) for 2 h. Methanol was used as a blank to determine the absorbance at 517 nm. The absorbance of the sample solution was recorded as Aa, and the absorbance of the blank was recorded as Ab. Trolox was dissolved in methanol with a concentration gradient of 0, 10, 20, 30, and 40 μg/mL [
25]. The antioxidant activity of the Msalais was expressed as μmol Trolox/L sample (Trolox equivalent).
2.7.2. Determination of ABTS Free Radical Scavenging Ability
The configuration of ABTS working solution was as follows: ABTS mother liquor with a concentration of 7 mmol/L and potassium persulfate solution with a concentration of 2.45 mmol/L were mixed in an equal volume ratio and placed in the dark for 12–16 h at room temperature (20–23 °C). The configured ABTS working solution was diluted to an absorbance of 0.700 ± 0.020 for use. The 0.1 mL sample was mixed with 3.9 mL of reaction solution and placed in the dark at room temperature (20–23 °C) for 30 min, with methanol used as a blank. A total of 200 μL of the mixed solution was added to a 96-well microtiter plate, and then the absorbance was measured at a wavelength of 735 nm. The absorbance of the sample solution was recorded as Aa, and the absorbance of the blank was recorded as Ab. The concentration gradient of water-soluble vitamin E (Trolox) was 0, 10, 20, 30, and 40 μg/mL [
26].
2.7.3. Determination of Total Oxygen Radical Absorbance Capacity (ORAC)
The sample solution, 20 μL of the Trolox standard solution, and 200 μL of fluorescein sodium solution (96 nmol/L) were added to a 96-well plate, and 20 μL phosphate buffer (100 mmol/L) was added to the blank control. After mixing, the sample was preheated at 37 °C for 20 min, and 20 μL of AAPH (153 mmol/L) solution was quickly added and mixed well. The 96-well plate was placed in a microplate reader for fluorescence intensity measurement. Determination conditions were as follows: excitation wavelength λ
excitation = 485 nm, absorption wavelength λ
emission = 535 nm, fluorescence value was measured every 2.5 min, a total of 35 cycles were used, and fluorescence intensity was recorded as f
1, f
2, … The f
35 value was subjected to Trolox calibration in each test, and the ORAC value of the sample was expressed as Trolox equivalent [
27].
4. Conclusions
In this study, we established an HPLC-ELSD method for the detection of Fru-Pro and Fru-Asp, screened a
Saccharomyces cerevisiae Y4 and a non-
Saccharomyces cerevisiae Y2, and verified the feasibility of the application of the two yeasts in the fermentation of Msalais. In order to obtain the best fermentation process of Msalais, the fermentation process optimized by the response surface method was as follows: fermentation temperature of 28 °C, fermentation time of 14 days, ratio of
Saccharomyces cerevisiae Y4 to non-
Saccharomyces cerevisiae Y2 of 2:1, and yeast inoculation amount of 2% (
V/
V). The contents of Fru-Pro and Fru-Asp were significantly increased by comparing Msalais with an unoptimized fermentation process, which was the same as the results of Li’s study [
45]. By comparing the antioxidant properties of self-made Msalais and commercial Msalais, the DPPH scavenging ability, ABTS scavenging ability, and ORAC of the self-made Msalais were significantly improved. The traditional fermentation method of Msalais is natural fermentation. Natural fermentation is a complex process involving the interaction of multiple microorganisms, which has instability and potential health risks. The yeast screened in this study can not only increase the content of Amadori compounds in Msalais but also improve the stability of the fermentation process. Compared with natural fermentation, the fermentation process is more convenient to control and eliminate potential health risks. Therefore, the fermentation of Msalais by specific yeasts has great application prospects. The results of this study can also provide a theoretical basis for the development of new products.
In this study, although the Msalais process optimization system was initially constructed and the directional enrichment of the target components was achieved, there are still many directions worthy of further exploration: only two Amadori compounds, Fru-Pro and Fru-Asp, were analyzed, and other Amadori compounds and other Maillard reaction products were not analyzed. The research has limitations. In the future, non-targeted methods (such as HPLC-MS and NMR) can be used to analyze Amadori compounds more comprehensively and to explore potential volatile components and toxic by-products. The regulation mechanism of key enzymes (such as aldose reductase, glycosyltransferase, etc.) in the dynamic process of the Maillard reaction on the formation of Amadori compounds can be further analyzed by molecular biology methods. Combined with metabolomics and sensory omics technology, the correlation model between Amadori compounds and Msalais flavor quality was established to achieve accurate regulation of product quality.